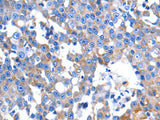
HINT2 Polyclonal Antibody Store at -20°C, Biomarkers, Elabscience Biotechnology, MSE Supplies

HINT2 Polyclonal Antibody Store at -20°C
SKU: E-AB-15710-200
HINT2 Polyclonal Antibody Store at -20°C
| SKU # | E-AB-15710 |
| Reactivity | Human |
| Host | Rabbit |
| Applications | IHC |
Product Details
| Isotype | IgG |
| Host | Rabbit |
| Reactivity | Human |
| Applications | IHC |
| Clonality | Polyclonal |
| Immunogen | Synthetic peptide of human HINT2 |
| Abbre | HINT2 |
| Synonyms | 1190005L05Rik, HINT-2, HINT-3, HINT2, HIT-17, HIT-17kDa, Histidine triad nucleotide-binding protein 2, PKCI-1-related HIT protein, Protein kinase C inhibitor 2, histidine triad nucleotide binding protein 2, mitochondrial |
| Swissprot | |
| Cellular Localization | Mitochondrion. |
| Concentration | 0.5 mg/mL |
| Buffer | Phosphate buffered solution, pH 7.4, containing 0.05% stabilizer and 50% glycerol. |
| Purification Method | Affinity purification |
| Research Areas | Signal Transduction |
| Conjugation | Unconjugated |
| Storage | Store at -20°C Valid for 12 months. Avoid freeze / thaw cycles. |
| Shipping | The product is shipped with ice pack,upon receipt,store it immediately at the temperature recommended. |
Related Reagents
| Applications | Recommended Dilution |
| IHC | 1:25-1:100 |
Background
Histidine triad proteins, such as HINT2, are nucleotide hydrolases and transferases that act on the alpha-phosphate of ribonucleotides.Hydrolase probably involved in steroid biosynthesis.May play a role in apoptosis.Has adenosine phosphoramidase activity.High expression in liver and pancreas.Expression is significantly down-regulated in hepatocellular carcinoma (HCC) patients.